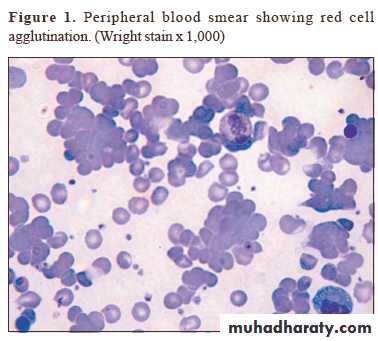

PNEUMONIA
TUCOMInternal Medicine
4th year
Dr. Hasan.I.Sultan
PNEUMONIA
Pneumonia is an acute infection of the lung parenchyma.CLASSIFICATION:
1- Aetiology.
2- Morphology: Bronchopneumonia vs. lobar pneumonia (which may be segmental, lobar or multilobar).
Lobar pneumonia: is a radiological and pathological term referring to homogeneous consolidation of one or more lung lobes, often associated pleural inflammation.
Bronchopneumonia: refers to more patchy alveolar consolidation associated with bronchial and bronchiolar inflammation often affecting both lower lobes
3- Community acquired vs hospital acquired (nosocomial) pneumonia.
4- The patient's immune status.
Pathology of lobar pneumonia
4 pathological phases;1-Congestion: 1-2 days. Pulmonary capillaries dilated and serous fluid leaks out capillaries into the alveoli. The patient is feverish with SOB and cough.
2-Red hepatization: 2-4 days. That is means the lung look like ‘red liver‘. The affected lobe is solid as the alveoli are full RBCs, neutrophils and fibrinous exudate instead of air, there is no gas exchange in this lobe. The patient becomes breathless and hypoxic. The cough is blood stained or rusty sputum.
3-Grey hepatization: 4-8 days. The affected part look like ‘grey liver‘. The alveoli are full of neutrophils and dense fibrous strands. The patient cough up of purulent sputum and remain breathless.
4-Resolution: Begins after 8-10 days (without antibiotics). Monocytes clear the inflammatory debris and normal air filled lung architecture is restored. Improvement of patient's condition.
Microscopic section of normal lung showing terminal bronchiole, respiratory bronchiole, alveolar duct, alveolar sac, and alveoli.
congestion+neutrophilic
Red hepatization
gray hepatisation
COMMUNITY-ACQUIRED PNEUMONIA (CAP)CAP: is pneumonia in patients living independently in the community.
The incidence varies with age, being much higher in the very young and the elderly
Most patients may be safely managed at home, but hospital admission is necessary in 20-40% of patients (5-10% of whom require intensive care)
CAP is usually spread by droplet infection and most cases occur in previously healthy individuals.
Factors that predispose to pneumonia
• Cigarette smoking• Upper respiratory tract infections
• Alcohol
• Corticosteroid therapy
• Old age
• Recent influenza infection
• Pre-existing lung disease
• HIV
• Indoor air pollution
Organisms causing community-acquired pneumonia
Bacteria
• Streptococcus pneumoniae
• Mycoplasma pneumoniae
• Legionella pneumophila
• Chlamydia pneumoniae
• Haemophilus influenzae
• Staphylococcus aureus
• Klebsiella pneumoniae
• Actinomyces israelii
Viruses
• Influenza, parainfluenza
• Measles
• Herpes simplex
• Varicella
• Adenovirus
• Cytomegalovirus (CMV)
• Coronavirus (SARS-associated coronavirus)
Microorganisms & clinical features of CAP
Common organisms
1- Streptococcus pneumoniae: The most common cause of classic or typical pneumonia.
Most common in winter. All age groups but particularly young to middle-aged.
Rapid onset of systemic features such as fever, rigors, shivering, herpes labialis, tachycardia and malaise predominate and delirium may be present.
Pulmonary symptoms include tachypnea, cough, which at first is painful and dry, but later accompanied by the mucopurulent or rust-coloured sputum, or occasionally hemoptysis.
Pleuritic chest pain may be a presenting feature.
Streptococcus pneumoniae are gram-positive cocci that occur in chains or pairs.
Herpes labialis and rusty sputum
•
2- Mycoplasma pneumoniae:
Most common in children and young adults. Common in autumn. Epidemics occur every 3-4 years.After (2–3 weeks) incubation period, fever and constitutional symptoms develop along with headache and cough, but pleuritic pain is uncommon.
Rare complications include haemolytic anaemia, Stevens-Johnson syndrome, erythema nodosum, myocarditis, pericarditis, meningoencephalitis, Guillain-Barré syndrome.
Grown on artificial media takes upwards of 2 weeks.
Mycoplasmal pneumoniae is one of the smallest organisms 125-150 μm . Is a pleomorphic organism that, unlike bacteria, lacks a cell wall, and unlike viruses do not need a host cell for replication.
Infection is spread form person to person by respiratory secretions expelled during bouts of
coughing, causing epidemic or sporadic occurrence.
Mycoplasma pneumoniae
Chest radiograph may show reticulonodular or interstitial infiltration, primarily in the lower lobes.
3- Chlamydia pneumoniae:
Young to middle-aged, large-scale epidemics, or sporadic, often mild, self-limiting disease. Headaches and a longer duration of symptoms before hospital admission.The pneumonia resembles that of Mycoplasma pneumonia in that patients often have prominent antecedent upper respiratory tract symptoms, fever, nonproductive cough, mild to moderate illness, minimal findings on chest auscultation, and small segmental infiltrates on chest x-ray.
Usually diagnosed on serology.
4- Legionella pneumophila:
Middle to old age, recent foreign travel, local outbreaks centered on contaminated cooling towers in hotels, hospitals and other industrial buildings. A variety of features are said to be more common such as nonproductive cough, headache, confusion, malaise, myalgia, high fever and diarrhoea.Laboratory results include hyponatraemia, elevated liver enzymes, hypoalbuminaemia and elevated creatine kinase. Chest X-ray appearances may be slow to resolve.
Legionella pneumophila:
are small, gram-negative, aerobic baclli.
Legionnaires’ disease is acquried by inhaling aerosolized water containing Legionella organisms or possibly by pulmonary aspiration of contaminated water. from humidifiers, shower heads.
Legionnaires' disease ; No diagnostic features on the chest X-ray distinguish it from other pneumonia. But may showing pulmonary infiltrates: Infiltrates can be unilateral, bilateral, patchy, or dense, and In sever illness it m. be multilobar involvement ,can spread very quickly to involve the entire lung.
Uncommon organisms;
1- Haemophilus influenzae:H. influenzae, an exclusively human pathogen, is spread by airborne droplets, its gram-negative coccobacillus.
Clinically indistinguishable from other types of bacterial pneumonia (e.g. Streptococcus pneumonia)
Often underlying lung disease (COPD, bronchiectasis)
2- Staphylococcus aureus:
Coexistent debilitating illness and often preceded by influenza. Radiographic features include multilobar shadowing, cavitation, pneumatoceles and abscesses. Dissemination to other organs may cause osteomyelitis, endocarditis or brain abscesses. Mortality up to 30%.
Staphylococci are gram-positive cocci, nonmotile, aerobic form grapelike clusters.
Chest X-ray show multiple lung abscess
Staphylococcus pneumonia
Klebsiella pneumoniae; a gram-negative baclli3- Klebsiella pneumonia: More common in aged men, malnourished and alcoholics. Upper lobe involvement typical. Low platelet count and leucopenia.
Atypical pneumonia; is an old term used to describe pneumonias where symptoms were more systemic (headache, malaise, joints pain, diarrhea) than pulmonary (cough, sputum, SOB). Atypical pneumonia was most often caused by pathogens such as Mycoplasma, Chlamydia, Legionella. as well as viral pneumonia.
Currently, it is recognized that symptoms do not reliably predict the infecting organism and that bacteria in atypical group commonly cause pneumonia.
Investigations
The main objectives of investigationsto obtain radiological confirmation of the diagnosis
to exclude other conditions that may mimic pneumonia
to obtain a microbiological diagnosis
to assess the severity of pneumonia
to identify the development of complications.
Note: many cases of mild to moderate CAP can be successfully managed without identification of the organism
Blood tests
Full blood count
• Very high (> 20 × 109/L) or low (< 4 × 109/L) white cell count: marker of severity
• Neutrophil leucocytosis suggests bacterial aetiology
• Haemolytic anaemia: occasional complication of Mycoplasma
Urea and electrolytes
• Urea > 7 mmol/L (~20 mg/dL): marker of severity
• Hyponatraemia: marker of severity
Liver function tests
• Abnormal if basal pneumonia inflames liver
• Hypoalbuminaemia: marker of severity
Erythrocyte sedimentation rate/C-reactive protein: Non-specifically elevated
Blood culture: Bacteraemia: marker of severity
Serology: Acute and convalescent titres for Mycoplasma, Chlamydia, Legionella and viral infections
Cold agglutinins: Positive in 50% of patients with Mycoplasma
Arterial blood gases
• Measure when SaO2 < 93% or when severe clinical features
to assess ventilatory failure or acidosis
Sputum
• Sputum samples for Gram stain, culture and antimicrobial sensitivity testing• Oropharynx swab: PCR for Mycoplasma pneumoniae and other atypical pathogens
Urine: Pneumococcal and/or Legionella antigen
Chest X-ray
• Lobar pneumonia: Patchy opacification evolves into homogeneous consolidation of affected lobe. Air bronchogram (air-filled bronchi appear lucent against consolidated lung tissue) may be present
• Bronchopneumonia: Typically patchy and segmental shadowing
• Complications: Para-pneumonic effusion, intrapulmonary abscess or empyema
• Staph. Aureus: Suggested by multilobar shadowing, cavitation, pneumatocoeles and abscesses
Pleural fluid: Always aspirate and culture when present
Lobar pneumonia
PA chest x-ray shows consolidation in the left lung base. A lateral view was obtained and shows that the consolidation is located posteriorly. Lateral view are especially important in showing infiltrates, which may be obscured by the heart on PA view.
Assessment of disease severity
Management
Rest and avoid smoking.Oxygen:
should be administered to all patients with tachypnoea, hypoxaemia, hypotension or acidosis. The aim of maintaining the PaO2 ≥ 8 kPa (60 mmHg) or SaO2 ≥ 92%. High concentrations (> 35%), preferably humidified.
Fluid balance:
Intravenous fluids should be considered in those with severe illness, elderly patients and those whose systemic features include vomiting.
Antibiotic treatment:
The choice of antibiotic is guided by clinical context, severity assessment, local knowledge of antibiotic resistance patterns, and at times epidemiological information.
Uncomplicated CAP; 7-10-day course is adequate.
Amoxicillin 500 mg 8-hourly orallyIf patient is allergic to penicillin
Clarithromycin 500 mg 12-hourly orally or
Erythromycin 500 mg 6-hourly orally
If Staphylococcus is cultured or suspected
Flucloxacillin 1-2 g 6-hourly i.v. plus
Clarithromycin 500 mg 12-hourly i.v.
If Mycoplasma or Legionella is suspected
Clarithromycin 500 mg 12-hourly orally or i.v. or
Erythromycin 500 mg 6-hourly orally or i.v. plus
Rifampicin 600 mg 12-hourly i.v. in severe cases
Severe CAP: for 10–14 days
Clarithromycin 500 mg 12-hourly i.v. or
Erythromycin 500 mg 6-hourly i.v. plus
Co-amoxiclav 1.2 g 8-hourly i.v. or
Ceftriaxone 1-2 g daily i.v. or
Cefuroxime 1.5 g 8-hourly i.v. or
Amoxicillin 1 g 6-hourly i.v. plus flucloxacillin 2 g 6-hourly i.v.
Treatment of pleural pain:
Relieve pleural pain in order to allow the patient to breathe normally and cough efficiently. Mild analgesics such as paracetamol are rarely adequate; however, opiates must be used with extreme caution in patients with poor respiratory function.
Complications
Para-pneumonic effusion-commonEmpyema
Retention of sputum causing lobar collapse
Development of thromboembolic disease
Pneumothorax-particularly with Staph. aureus
Suppurative pneumonia/lung abscess
ARDS, renal failure, multi-organ failure
Ectopic abscess formation (Staph. aureus)
Hepatitis, pericarditis, myocarditis, meningoencephalitis
Pyrexia due to drug hypersensitivity
Discharge and follow-up
Discharge clinically stable with clinical review after 6 weeks
No discharge in the presence of more than one of the following clinical signs: temperature > 37.8°C, heart rate > 100/min, respiratory rate > 24/min, systolic BP < 90 mmHg, SaO2 < 90%, inability to maintain oral intake and abnormal mental status. New CXR should be obtained.
HOSPITAL-ACQUIRED PNEUMONIA (HAP)
HAP or nosocomial pneumonia refers to a new episode of pneumonia occurring at least 2 days after admission to hospital.Usually in elderly patients, patients in intensive care units, (especially when mechanically ventilated) and post-operative patients.
The factors predisposing to HAP are: Reduced host defences against bacteria. Aspiration of nasopharyngeal or gastric secretions. Bacteria introduced into lower respiratory tract. Bacteraemia.
Aetiology: the common pathogens are:
• Gram-negative bacteria, includes Escherichia, Pseudomonas and Klebsiella species.
• Staph. aureus (including multidrug-resistant-MRSA-forms)
• Anaerobic organisms.
Clinical features and investigations:
the diagnosis of HAP should be considered in any hospitalized or ventilated patient who develops:Purulent sputum
New radiological infiltrates
Unexplained increase in oxygen requirement
Body temperature of more than 38.3°C
Leucocytosis or leucopenia.
The clinical features and radiographic signs are variable and non-specific, therefore, in contrast to CAP, microbiological confirmation should be sought whenever possible.
Chest X-ray shows mottled opacities in both lung fields, chiefly in the lower zones (Bronchopneumonia).
Management of HAP
A third-generation cephalosporin (e.g. cefotaxime) plus an aminoglycoside (e.g. gentamicin) to cover Gram-negative bacteria, including Pseudomonas.Antipseudomonal agents e.g. carbapenem (meropenem)
A monocyclic β-lactam (e.g. aztreonam) plus flucloxacillin to cover Staph. aureus.
Vancomycin to cover MRSA
Metronidazole to cover anaerobic organisms.
Physiotherapy ,adequate oxygen therapy, fluid support and monitoring are essential.
The mortality from hospital-acquired pneumonia is high (approximately 30%).
Severe acute respiratory distress syndrome (SARS)
Corona virus, is an RNA virusSARS rose to prominence in late 2002 in China. followed by an international outbreak
high fever (> 38°C), malaise and muscle aches and later a dry cough with shortness of breath or difficulty in breathing, with history close contact within 10 days of onset of symptoms with a person known to be a suspect SARS case is typical.
The chest X-ray is usually indicative of pneumonia.
A rapid diagnosis of SARS-CoV infection can be made by PCR. Serum antibodies can be detected by ELISA.There is no specific therapy of established efficacy for SARS, although ribavirin has frequently been used. It’s treatment remains largely supportive, to maintain pulmonary and other organ system functions.
Chest x-rays of a 46-year-old man with SARS. The left lower lung infiltrate seen initially (A) progressed to multiple bilateral opacities (B).